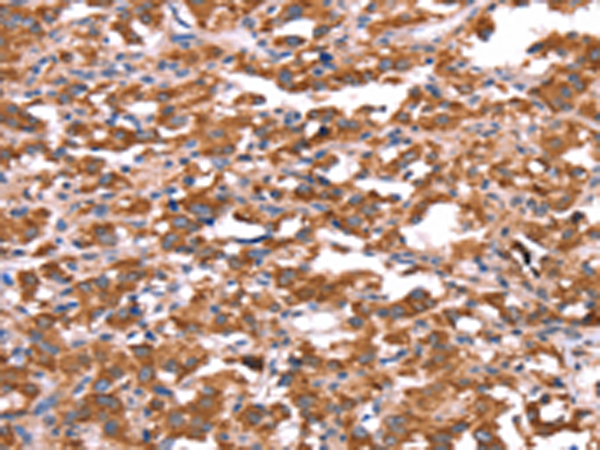
一抗

Background:
The protein encoded by this gene is an RNA binding protein that interacts with the functionally-similar proteins FMR1 and FXR2. These proteins shuttle between the nucleus and cytoplasm and associate with polyribosomes, predominantly with the 60S ribosomal subunit. Three transcript variants encoding different isoforms have been found for this gene
Applications:
ELISA, IHC
Name of antibody:
FXR1
Immunogen:
Synthetic peptide of human FXR1
Full name:
fragile X mental retardation, autosomal homolog 1
Synonyms:
FXR1P
SwissProt:
P51114
ELISA Recommended dilution:
1000-2000
IHC positive control:
Human thyroid cancer and Human gastric cancer
IHC Recommend dilution:
25-100

 購(gòu)物車
購(gòu)物車 幫助
幫助
 021-54845833/15800441009
021-54845833/15800441009